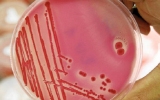

EXCESS OF WEIGHT BEFORE 50 YEARS, CAN INCREASE THE RISK OF SUFFERING PANCREAS CANCER
Excess weight before age 50 may be more strongly associated with the risk of mortality from pancreatic cancer than excess weight at older ages, according to the results of a study presented at the Annual Meeting of the American Research Association Against Cancer (AACR) 2019, which is celebrated until Wednesday.
1 / 4 / 2019
45,000 NEW CASES OF CANCER OF COLON IN SPAIN
The University Hospital of Navarra has organized a colloquium on colon cancer next Wednesday in Pamplona, the most frequent tumor in developed countries. In Spain, 45,000 new cases are diagnosed each year, according to the Spanish Society of Medical Oncology.
25 / 3 / 2019
It is estimated that up to 4 million people in Spain hide a problem of urinary incontinence due to embarrassment or resignation, as the General Council of Nursing recalled on the occasion of the commemoration, this Thursday, of the International Day of Urinary Incontinence. associated with urinary incontinence leads patients to avoid talking about it, which can not be assessed or adequately controlled, "according to the agency, which adds that incontinence is seen as a health problem" that does not gravity not compromising the patient's life, and even perceived as a normal consequence associated with the aging process ".
18 / 3 / 2019
MAMMARY RECONSTRUCTION AFTER A BREAST CANCER
The way to define the type of scar or the type of surgery that is necessary depends on each woman. Also of the physical texture of each of them, the type of cancer and whether there is the possibility of immediate reconstruction or not. All this makes the breast surgeon choose a type of scar depending on what is best for each patient.
11 / 3 / 2019
CRYOSURGERY AND SKIN CANCER
Dr. Paola Pasquali (Venezuela, 1960) is an international leader in skin diseases, especially in tumors. To treat them, this specialist works in the field of cryosurgery, a technique that spreads with talks and presentations in hospital centers around the world. She is currently the coordinator of Dermatology at the Pius de Valls Hospital. When she arrived, in 2008, there was a waiting list of 3,000 dermatological patients. Currently, it does not exist.
4 / 3 / 2019
DATA TO ALWAYS KEEP IN MIND ABOUT CANCER
Cancer, a pathology of which more than 277,000 new cases will be diagnosed this year, according to oncologists, which predict an increase in the incidence of disease due to the aging of the population, exposure to risk factors such as smoking and early detection. Due to these factors, cases have increased by 12% in the last four years and, by sex, in women the percentage exceeds 17%, twice that of men (8.2%), due to the later incorporation of them to the habit of smoking, according to the estimations of the Spanish Society of Medical Oncology (SEOM).
25 / 2 / 2019
FIGHT AGAINST CHILDHOOD CANCER
In the Children's Cancer Day, CRIS Against Cancer and the C & A Foundation have presented a project that aims to fight against childhood cancer. For the first time in Spain, a specialized fellowship in pediatric hemato-oncology training has been developed by CRIS, which has been delivered to the primary care pediatrician, Dolores Corral. The doctor has just begun her training at the CRIS Unit for Research and Advanced Therapies of Childhood Cancer at the Hospital de la Paz.
19 / 2 / 2019
NEW INCIDENCE OF LUNG CANCER IN WOMEN
The latest report of the Spanish Society of Medical Oncology (SEOM) has raised the alarm in the incidence of lung cancer in women. Its incorporation into tobacco for decades has now translated into an unchecked escalation in the number of tumors diagnosed in women. They are already the third most frequent in them, when a few years ago they hardly appeared among the top ten. The mortality associated with this cancer, in addition, means that although the cases diagnosed are far from those of the breast and colon, the number of deaths is less so.
12 / 2 / 2019
INTERNATIONAL DAY OF CANCER, TO CONTINUE WORKING
On Monday, February 4, the International Cancer Day was celebrated, a date in which to compile the impact of this disease on society. Cancer is, today, the second cause of death in Spain, only behind the diseases of the circulatory system, according to data from the National Institute of Statistics in December 2018, corresponding to the year 2017.
4 / 2 / 2019
EL CÁNCER DE PRÓSTATA Y SU DIAGNÓSTICO
In Mexico, around 7,000 men die annually due to prostate cancer; On average, 14 die every day. This disease, recognized as the most common malignant tumor among men over 50, is even ahead of lung cancer. According to Dr. Juan José Real Cárabes, every year up to 25 thousand new cases are diagnosed, however, it can be curable in 90% of cases if detected on time.
28 / 1 / 2019
PROSTATE CANCER IMPROVES ITS SURVIVAL
Prostate cancer is the second most frequently diagnosed tumor in Spain (first in males), with approximately 33,370 new cases per year in Spain and 359,942 in the European Union, however, there are increasingly more data regarding survival, which according to the Society Spanish Medical Oncology (SEOM) are due to pharmacological advances and radiotherapy.
14 / 1 / 2019
THE EARLY DETECTION OF MELANOMA
Dr Romy Giardina, a dermatologist, explains that there are two most frequent types of skin cancer: non-melanoma - which is composed of basal cell carcinoma and squamous cell carcinoma - and melanoma. The prognosis of cure depends on early detection and correct removal.
17 / 12 / 2018
SEXUAL RELATIONS CAN ALSO HELP TO DETECT A POSSIBLE PROSTATE CANCER
Official figures from the center for the prevention and control of diseases in the United States indicate that more than 250,000 men a year are diagnosed with prostate cancer, the worst of all is that due to cultural issues, fear, ignorance or simple lack of time they do not visit a specialist to help them obtain an opportune diagnosis.
10 / 12 / 2018
3 / 12 / 2018
A POTENTIAL DIANA HAS BEEN FOUND TO DEAL WITH PANCREAS CANCER
A research led by the Idibaps Institute and the Center for Genomic Regulation (CRG) has discovered a new potential target to treat the most common type of pancreatic cancer. Identified from samples of patients and mice, it is a protein that contributes to the growth of tumor cells, according to Gut magazine.
26 / 11 / 2018
LUNG CANCER: PRIORITY FOR A TUMOR IN THE SHADOW
The Spanish Lung Cancer Group, formed by more than 450 specialists, has launched a manifesto and an awareness campaign to enhance the involvement of the administration and society in a tumor that holds the first place in mortality and the second in incidence but, nevertheless, "it is one of the most invisible", according to a statement from the GECP.
19 / 11 / 2018
NOVEMBER, MONTH OF PROSTATE CANCER
October is the month of the fight against breast cancer, November is considered as the month against prostate cancer, a disease that attacks mainly from 50 to 65 years of age. Like breast cancer, the prostate is curable if detected early and for this it is recommended that revisions be made as of 45 years as indicated by Dr. Enrique Campos director of the Health Center in Tecate.
13 / 11 / 2018
CRYOSURGERY, ALSO FOR SCARS
The wounds, injuries produced in any part of the body (skin, muscle, nerve), are caused by the manipulation of sharp elements, falls, blows or accidents. When treating a wound it is necessary to identify what type of wound it is, since it can be differentiated between chronic or acute, and superficial or deep.
5 / 11 / 2018
30 / 10 / 2018
CLIMATERIO, MULTIFACTORIAL STAGE IN THE LIFE OF WOMEN
If we investigate in the dictionary, we will see that the word Climacteric comes from the Greek Klimater, which means step and describes a period of transition that lasts for years, before and after menopause, as a consequence of ovarian exhaustion, associated with a decrease in the production of estrogen in which the ovary loses over years the ability to produce hormones, follicles and oocytes. In women, it is often confused with menopause, which is the last menstruation.
23 / 10 / 2018
LAST GOODBYE TO JOSE ANTONIO FRIAS
Life had also reserved at first José Antonio a few rough ballots, as most of those who looked at the world in a humble family in the Axarquía of the 50s. In the hamlet of Mondrón few believed that life was that tombola full of light and color who heard him sing to Marisol in black and white. Regarding health information, he was always a courageous precursor.
15 / 10 / 2018
UROLOGIST PEDRO TORRECILLAS, RECOGNIZED BY THE RAMÓN AND CAJAL SCIENCE ACADEMY
The Academy of Health Sciences Ramon y Cajal has recognized the urologist Pedro Torrecillas for his career in the world of medicine, as well as incorporating him into this institution as a number academic. This distinction has been granted "for being a pioneer in Europe in the use of the green laser for the treatment of benign prostatic hyperplasia, one of its great specialties, and for being one of the main promoters of the cryosurgery technique in the treatment of various tumors. "
8 / 10 / 2018
MESOTHELIOMA EMERGING TREATMENTS AND RESEARCH
Treatment is an ongoing challenge for patients with mesothelioma and for the specialists that care for them. One of the biggest challenges is that it is often diagnosed in later stages. This is because symptoms take years to develop, and when they do they mimic more common illnesses, including lung cancer in the case of pleural mesothelioma.
5 / 10 / 2018
THE PRESS ECHOES ADVANCES IN CRYOSURGERY
The International Center for Cryosurgery and Cryotherapy, located in Malaga, applies the technique of freezing and eliminating tumors in a natural way, with a "clean, minimally invasive surgery for the human body and minimal side effects" and advances and results have motivated their studies to be analyzed at the International Cryosurgery Forum in Bucharest; recently celebrated
1 / 10 / 2018
BREATH FOR THE MOST WRESTLING PATIENTS
"After many years of honest and rigorous journalism I must recognize that, in effect, the FAIRS exist. I know because I have one at home. Her name is Ibai, she is my 15 year old daughter, and she has just overcome a Bone Cancer because she never, never, lost the Light. It has been a horrible year but we won. I love you my girl. Thanks to the medical team of the Niño Jesús Hospital in Madrid and to our Public Health. And thanks to all the elves and nymphs that gave birth to her and made her smile during her illness ... Thanks to everyone for being there. Ibai and I are back !!!"
24 / 9 / 2018
THE PROGRESS MADE IN THE INTERNATIONAL CENTER OF CRIOMEDICINA OF MALAGA, REFERENCES OF THE INTERNATIONAL FORUM OF CRIOCIRUGIA OF BUCHAREST
The International Center for Cryosurgery and Cryotherapy, located in Malaga, applies the technique of freezing and eliminating tumors in a natural way, with a "clean" surgery, minimally invasive for the human body and minimal side effects. The advances and positive results have motivated their studies to be analyzed in the International Cryosurgery Forum in Bucharest; recently celebrated
22 / 9 / 2018
ROUTINE EXAMS AND PROSTATE CANCER
According to a panel of international experts in an article published in 'BMJ', routine tests for prostate cancer are not recommended for most men because the benefit is small and uncertain and there is obvious damage. Routine tests for prostate cancer are not recommended for most men because the benefit is small and uncertain and there is obvious damage, according to a panel of international experts in an article published in 'BMJ'.
10 / 9 / 2018
CYTOLOGY TO DETECT UTERUS NECK CANCER
The United States Preventive Services Task Force (USPSTF) has published new recommendations on the detection of cervical cancer, which continues with the tendency to decrease the frequency of Pap tests, which since its introduction 75 years ago it was the standard screening test for this tumor.
3 / 9 / 2018
BREAST CANCER DOES NOT UNDERSTAND AGES
The Pan American Health Organization (PAHO) states that in 2012, more than 408,000 women were diagnosed with breast cancer in America, and 92,000 of them died from this disease. Therefore, the subject, according to specialists, must be in debate every month of the year, because it must provide increasingly specialized solutions.
13 / 8 / 2018
LOSS OF URINE, THE FORTY AND THE PROSTATE
We put the focus today on male urinary incontinence. And the data is surprising, since urinary incontinence is lived in silence or even with shame. And this should not be the case, most of those affected admit that they are ashamed and hide it or even avoid talking about it with their own doctor, so that incontinence takes time to be diagnosed and treated.
6 / 8 / 2018
IMPROVEMENTS IN THE SURVIVAL OF KIDNEY CANCER
Kidney cancer has been considered for years as a low incidence neoplasm, whose surgical treatment was the only effective way to control the evolution of patients. It represents 3 percent of all tumors, and approximately three out of four renal neoplasms will be clear cell carcinomas. It is approximately twice as frequent in men as in women and the average age of presentation is at 60 years.
2 / 8 / 2018
MYTHS ABOUT SEXUAL LIFE AND PROSTATE CANCER
There are many men who, in front of a sign of alarm of some disease, do not go to a specialist to have a medical check-up. This is mostly due to shame, fear or disinformation. It is known that 1 in 9 men in the world will be diagnosed with prostate cancer during the course of their lives and in Peru 40% of cases are detected in advanced stages, according to the American Cancer Society.
2 / 7 / 2018
HAVING SEX WITH FREQUENCY HELPS PREVENT PROSTATE CANCER
Having sex often helps prevent prostate cancer. It is something that has always been heard, but that is increasingly more settled scientifically. Prostate cancer is the second leading cause of death from cancer in men in the United States. It is estimated that 26,120 deaths will occur this year due to this disease. In addition, according to statistics presented in 2017, this year about 180,000 men will be diagnosed with prostate cancer in the United States.
25 / 6 / 2018
HOW TO TAKE 'TRASH FOOD' FOR YOUR DIET TO BE HEALTHY
Pleasant to the palate, very accessible and unhealthy. Hamburgers, pizzas and other foods considered as 'junk food' and / or ultraprocessed because they contain additives in their composition, such as refined flours, added sugars or refined vegetable oils, are very present in the diet of many people. It is widely known that they are very caloric and imply health risks, according to multiple scientific studies in which, even, their consumption has been associated with an increased risk of cancer.
18 / 6 / 2018
WORLD DAY AGAINST PROSTATE CANCER
Many times when we are in situations of relative stability or tranquility we forget what it has cost to get it. World Cancer Day of the Prostate is celebrated every June 11, a type of tumor that a large part of society perceives as relatively innocuous and less serious than others. It is not uncommon, after all the survival rates are very high, and there are very effective treatments for most patients. But things have not always been that way.
11 / 6 / 2018
5 / 6 / 2018
TREATMENT AGAINST LIVER CANCER
According to data from the Spanish Society of Medical Oncology (SEOM), in 2017, 5,878 new cases of liver cancer were diagnosed in our country, especially in men and people over 50 years of age.
28 / 5 / 2018
HOW A PANCREAS IS COMPOSED AFTER A CANCER SURGERY
After the intervention, patients typically experience a two-week period during which their immune system is depleted as a result of an increase in postoperative stress hormone (cortisol) levels. With killer T cell levels decreasing, latent and isolated cancer cells that have already traveled to the liver and possibly other organs through the bloodstream begin to grow or metastasize.
21 / 5 / 2018
15 / 5 / 2018
PHYSICAL EXERCISE BECOMES THE MOST IMPORTANT FACTOR FOR THE PREVENTION OF CANCER
Physical exercise should be part of the treatments for cancer patients because it helps to counteract the adverse effects of the disease and the therapies that are applied, has assured the Oncological Clinical Society of Australia.
8 / 5 / 2018
IMPROVING THE DIAGNOSIS WITH CRYOSURGERY
The Tlaxcalteca Institute for Specialized Health Assistance (Itaes) offers highly specialized diagnostic studies to the population that requires this service. Itaes has biomedical equipment and modules for microbiology and clinical analysis, for women and imaging, where patients who go directly or are referred by a doctor are treated.
23 / 4 / 2018
PREVENTION AGAINST CANCER, FROM CHILDREN
A new study published in the 'Journal of Pediatrics' shows that weight gain can have a negative impact on liver health in children up to eight years.
10 / 4 / 2018
SUN RISES IT IS THE BEST TIME TO PREVENT SKIN CANCER
Did you know that the skin is the largest organ in the human body? It is the layer that separates our internal organs from the environment and protects from possible environmental damage, but in it, some type of cancer can also appear if the necessary care is not taken. Each year skin cancer diagnoses are on the rise, and this is one of the three most common cancers in the world.
2 / 4 / 2018
AGAINST UTERUS NECK CANCER, PREVENTION
The best weapon to fight against cervical cancer is prevention. The proof: Cases of incidence in Venezuela have decreased, due to the continuous campaigns of screening. It is the third cause of mortality in the world, and in our country it is the second cause after breast cancer Cervical cancer or cervical cancer originates in the cells that line the cervix, the lower part of the uterus (womb).
27 / 3 / 2018
SOYA PROTECTS PROSTATE CANCER
Prostate cancer is the second most diagnosed type of cancer in men and represents 15% of all male cancers worldwide. Some studies had previously pointed to a possible protective effect of soybean against this type of cancer, which would fit with the fact that in Asian countries, where abundant soy is consumed, the incidence is lower.
19 / 3 / 2018
THE VIRUS OF HUMAN PAPILOMA IN MEN
A man infected with the human papilloma virus (HPV) can infect his sexual partner even when he has no visible symptoms of the condition in his genitals. Many people do not know, but HPV is the most common sexually transmitted disease, and both men and women are at risk, and cryosurgery is also effective in supporting treatment.
12 / 3 / 2018
NEUMOVIDA AND CRIOSURGERY IN LUNG CANCER
Neumovida was born 20 months ago with the idea of making a specialized respiratory center in which patients could find all the tools and treatments that can be done in Colombia to treat respiratory diseases, in the west of the country it is the first center that a single site can address all pathologies with existing technologies, there are only some similar ones in Bogotá and Bucaramanga.
6 / 3 / 2018
WHEN PROSTATE CANCER ARRIVES IN YOUTH
If you are a man under 30, you have pain in your back, hip or pelvis, you wake up at midnight to urinate frequently and feel pain or burning when urinating. Be alert! Prostate cancer may be at the door. In general, this condition carries the "label" of appearing only in older adults, between 50 and 55 years. And of course yes, the largest population of this cancer are men of advanced age, but in certain cases it is not like that.
26 / 2 / 2018
THE PATIENT OF PROSTATE CANCER IS EVER MORE YOUNG
The profile of the patient with prostate cancer has been rejuvenated in recent years and has done so because men do more tests and attend more to mild symptoms when they manifest, although it is common that this pathology is asymptomatic.
19 / 2 / 2018
FOCAL THERAPY, DIFFERENT TREATMENTS FOR PROSTATE CANCER WITH THE SAME OBJECTIVE
Focal therapy proposes treating prostate cancer with an approach similar to that of other malignancies in solid organs, where the treatment is directed to the area of the cancer and surrounding normal tissues, in order to preserve tissue and, as a consequence, the organ function. By avoiding damaging the entire prostate, the risk of altering the nerves, muscles, urinary sphincter, bladder and rectum can be greatly reduced.
12 / 2 / 2018
KEYS TO A FOOD THAT HELPS PREVENT CANCER
Research has shown that a healthy diet can reduce the risk of certain cancers. It can also prevent other conditions, such as type 2 diabetes, osteoporosis and heart disease. One of the benefits of good nutrition is that it helps us maintain a healthy weight. People who are overweight or obese run the risk of having more health problems. A diet high in fiber and low in fat, and regular exercise can help you lose weight and not get it back.
5 / 2 / 2018
29 / 1 / 2018
FOOD IS BACK TO BE A KEY TO A LIFE WITHOUT CANCER
When any prostate cancer loses a specific gene, it becomes a small fat factory, a team at Beth Israel Deaconnes Medical Center in Boston reported in a paper published in Nature Genetics. Scientists know that obesity is linked to prostate cancer, but it is not clear why. This week the researchers reported the finding of a surprising connection.
24 / 1 / 2018
APPLYING COLD REDUCES PAIN AND HELPS IN INJURIES
It's here. It has been done to pray but it seems that, finally, winter has reached the Peninsula and not just the calendar. And with it the extreme cold that, although it is true that suffering trapped in a highway does not seem the most advisable, applied by expert hand and professionally has positive consequences on health. Medicine knows this and relies on low temperatures to treat multiple ailments, hence the importance and effectiveness of methods such as cryosurgery.
17 / 1 / 2018
FREEZING TUMORS, KEY IN TREATMENTS AND CANCER RESEARCH
Freezing tumors is consolidated, both for extirpation and treatment; as for your research for the future. The pathological anatomy service is the great unknown and at the same time of vital importance to obtain the definitive diagnosis of a great part of the ailments that the patients have, both those admitted and the ambulatory ones.
9 / 1 / 2018
13 / 9 / 2017
A STUDY REVEALS THAT MORE THAN 22,000 MEN IN MALAGA WILL SUFFER BENIGN PROSTHETH HYPERPLASIA
A study by the International Center for Cryosurgery and Criomedicine, based in Malaga, reveals that 50 percent of men over 60 will suffer from benign prostatic hyperplasia, ie inflammation or enlargement of the prostate, something that Affects more than 22,000 men in the province. MORE INFORMATION
19 / 5 / 2017
SOCIAL WORK AGAINST CANCER, ALSO IN THE LITERATURE
This book, 'Believe me, it is possible to face cancer with optimism', is being a fundamental tool for that work that is so important to overcome a cancer, the social. The data and the perception of readers is being very positive.
6 / 3 / 2017
IMMUNOTHERAPY IS THE PRESENT AND WILL BE ABLE TO ELIMINATE CANCER
Oncologist Elisabeth Pérez, only 35, has received the research award from AECC Carmen Lavigne. With the award, the project 'Implementation of a clinical trial of cancer immunotherapy with semialogenic NK lymphocytes' will be developed for 12 months. The goal is to multiply the good cells that attack the malignant and responsible tumors.
25 / 1 / 2017
IDENTIFY A COMPONENT THAT COULD PREVENT THE METASTATICS OF THE PANCREATIC CANCER
Oliver McDonald, assistant professor of Pathology, Microbiology and Immunology at Vanderbilt University School of Medicine, and a group of colleagues are responsible for this study in which they further assert that the finding would prevent the formation of tumors. To date, there has been no "evidence of other agents acting selectively on aggressive metastatic diseases" according to that expert.
18 / 1 / 2017
DISCOVER THE MOLECULAR CAUSES THAT MAKE SOME TYPES OF PROSTATE CANCER SO AGGRESIVE
Investigadores de la Universidad de Monash (Australia) han liderado un estudio en el que han descubierto que el cáncer de próstata es más agresivo en aquellos hombres con antecedentes familiares de este tumor, que además presentan una alteración en el gen BRCA2, según detallan en la revista 'Nature Communications'
16 / 1 / 2017
FIND HOW TO PREVENT IF A PROSTATE CANCER WILL REQUIRED OR NOT AGGRESSIVE TREATMENT
Each year more than 30,000 new cases of prostate cancer are diagnosed in our country, the second most prevalent type of tumor in the Spanish population and the first in men. The good news is, as the data of the Spanish Society of Medical Oncology (SEOM) show, that the five-year survival associated with this cancer is the highest among all the most frequent tumors - up to 84.6% in the Patients diagnosed between the years 2000 and 2007-. More information.
30 / 1 / 2017
SPANISH RESEARCHERS FIND A MECHANISM TO REDUCE THE RECURRENCE OF BREAST CANCER
Researchers at the Institute of Biomedical Research at Bellvitge (Idibell) have shown in mouse animal models that the pharmacological and genetic inhibition of a protein leads to a significant reduction in breast cancer recurrence and metastasis in this type of tumor. More information
29 / 12 / 2016
THINGS TO AVOID WHEN YOU SPEAK WITH A SICK CANCER PERSON
It is long since the word 'Cancer' is in our lives, because of the information that surrounds us and because it is rare not to have a close case of friends or family. When talking to these patients, there are certain phrases, words and issues that the diagnosed patient prefers to avoid. This psychological work is very important.
24 / 11 / 2016
WHAT ARE THE LESS VISIBLE SYMPTOMS IN BREAST CANCER
Bulging or inflammation is often the clearest sign or symptom of the possibility of breast cancer. This inflammation is not the only sign. Changes in the nipple and many other evidences, according to this information of the bbc.com news portal, can put us in the track of the detection of these symptoms.
15 / 11 / 2016
THE STAIN ON THE SKIN, HOW TO DISCOVER IF THEY RELATE TO A CANCER
Cosmetic laboratories are aware that skin blemishes are one of the biggest concerns of women's facial care in Spain. Although the sun is the one that almost always potentiates them, the origin or cause of their appearance is very varied. Before the mirror and, ready to end it, ask yourself: what is my stain? Only then will you know how to go for it. And know the relationship they can have with skin cancers and what role can cryosurgery play in that context.
15 / 11 / 2016
18 / 11 / 2016
DELAYING THE FIRST PREGNANCY INCREASES THE POSSIBILITIES OF SUFFERING A BREAST CANCER
"In recent years we have seen an increase in the number of cases of gestational breast cancer, probably associated with the delay of the age of the first pregnancy. The profile of the patient is a woman with a late pregnancy after the age of 30, and in which a rapid tumor growth is observed" said Dr. Juan de la Haba, a medical oncologist and director of the Breast and Clinical Research Unit of the Reina Sofía University Hospital in Córdoba.
24 / 11 / 2016
HEALTH CONVERSES OCTOBER IN THE BREAST CANCER AWARENESS MONTH
Junta de Andalucia, University of Almería (UAL), Provincial Board of the Spanish Association Against Cancer (AECC) and the Association of Mastectomized Women of Almeria (Amama) have organized a program of activities for October, with Reason for the celebration of the month of the Fight against Breast Cancer.
28 / 11 / 2016
2 / 12 / 2016
IDENTIFY A NEW THERAPEUTIC DIANA IN LIVER CANCER
Researchers in Catalonia have described an epigenetic mechanism responsible for the activation of a cellular receptor in hepatocellular carcinoma, the IGF2 factor, with samples from 228 patients. This alteration is present in 15% of the tumors; A monoclonal antibody effectively blocks it and slows tumor progression in animal models. More info.
5 / 12 / 2016
ONLY 20% OF COLON CANCER'S DIANA POPULATION HAS BEEN SUBMITTED TO THE SCREENING TEST
Only the 20 percent of the target population invited in Almería to undergo a colon cancer screening within the Early Diagnosis Program of this disease has been tested. In the period from October 2015 to September, 931 people from a target population of 5,187 were tested. More information.
7 / 12 / 2016
29 / 12 / 2016
A TRADITIONAL CHINESE REMEDY AGAINST CANCER
A team of researchers from the Australian University of Adelaide has just demonstrated in a study that an ancient herbal remedy of traditional Chinese medicine is tremendously effective at destroying tumor cells. The herbal compound is approved in the Asian country for the treatment of various kinds of cancers, and is commonly used alongside "western" chemotherapy. What surprises the researchers is that, despite its proven effectiveness, it is completely ignored how it works. Más información.
11 / 1 / 2017
6 / 3 / 2017
GIVE FIGHT AGAINST CANCER IN YOUR WEDDING
There are many details that have solidary people in your life, and in regards to the fight against cancer as well. We have received donations from NGO collections, solidarity projects in the Third World, or gifts of other kinds. On this occasion, Paola and Luca have decided to donate what they had planned to spend on the details of memory for research organizations...
14 / 3 / 2017
FIND A WEAK POINT IN THE 'ARMORING' OF THE MOST AGGRESSIVE LUNG CANCER
Researchers at the University of Virginia School of Medicine have discovered a defect in the "armor" of the most aggressive form of lung cancer that may be a weak point to slow or stop the disease. Surprisingly, this vulnerability is derived from the very aggressiveness that makes cancer so deadly. Más información
20 / 1 / 2017
TIPS TO LEAVE THE SKIN AFTER A SOLAR BURN
In summer we all expose ourselves to the sun; even those who shy away from the beach or the pool run the risk of being burned by simply wandering around the city or having a drink on a terrace. It is very important to be aware of the need to wear sunscreen, mainly on the face, and unlike popular beliefs, not only in summer but all year round.
15 / 3 / 2017
CANCER IS NOT A MODERN DISEASE: THE OLDEST ARE, THEY ARE ALMOST TWO MILLION YEARS OLD
A team of scientists from the University of Witwatersrand (Johannesburg) and the South African Center for Excellence in Paleoscience have found the earliest evidence of cancer in humans. The metatarsal of a 1.7 million-year-old fossilized foot found in Swartkrans's South African cave, about 40 kilometers northwest of Johannesburg, has been revealed in a statement.
16 / 3 / 2017
IMMUNOTHERAPY ADVANCES AGAINST CANCER
In a breakthrough that opens the way to improving immunotherapies against cancer, researchers at the University of California at Los Angeles (UCLA) led by Antoni Ribas have discovered why some tumors become resistant to treatment. According to the results presented online in the journal The New England Journal of Medicine, immunotherapy drugs push some cancers to evolve to escape the attack of the immune system. Thus, an arms race between cancer cells and immune cells is triggered so that they prime them. More information.
20 / 3 / 2017
5 SKIN CANCER ALERT SIGNS AND 5 ADVICE TO AVOID IT
Laura Vidal, a collaborating oncologist at the Helping Cancer Association, explains the warning signs of possible skin cancer and advises on what precautions to take to prevent it. He says that the relationship that our society has established between tanning, beauty and health is causing the rate of skin cancer to increase.
22 / 3 / 2017
SCIENTISTS OBSERVE FOR THE FIRST TIME HOW SKIN CANCER IS BORN
A team of scientists from the University of Cambridge (UK) and the Free University of Brussels (Belgium) have for the first time seen how a tumor is born in the skin from the first "cell of origin" and have observed its Training process.
24 / 3 / 2017
KATAEGIS IMPROVES THE RESULTS OF BREAST CANCER
A genetic phenomenon called kataegis is a positive marker in breast cancer, since patients with these "hot spots" of mutation have less invasive tumors and a better prognosis. This has been discovered by researchers from the University of California (UC) School of Medicine in San Diego and the Moores Cancer Center in the United States using a genomic database of human tumors.
27 / 3 / 2017
A THREE THERAPY ACHIEVES INCREASING SURVIVAL IN PANCREATIC CANCER
Each year more than 4,000 new cases of pancreatic cancer are diagnosed in our country, a type of tumor that, although tenth in frequency, is the fourth cause of mortality due to any cancer disease. In fact, pancreatic cancer has the lowest survival rate associated with any tumor, with only 6% of patients surviving five years after diagnosis.
29 / 3 / 2017
CLINIC COMES FIRST PROGRESS AGAINST LIVER CANCER IN NINE YEARS
The drug regorafenib significantly prolongs survival in people with liver cancer who do not respond to other treatments, according to an international study led by Hospital Clínic.
31 / 3 / 2017
THE SURVIVAL OF CHILD CANCER IN SPAIN IS BELOW THE EUROPEAN
Each year, in Spain, about 1,600 new cases of cancer are diagnosed in children (between 350 and 400 are adolescents). Survival in Spain is high, but "something is happening that our results on survival in childhood cancer are not improving," according to Dr. Ana Fernández-Teijeiro, who chairs the Spanish Society of Hematology and Pediatric Oncology (SEHOP).
3 / 4 / 2017
PROBIOTICS TO PROTECT BREAST CANCER?
Bacteria that have the potential to instigate breast cancer are present in the breasts of cancer patients, while beneficial bacteria are more abundant in healthy breasts where they may actually be protecting women from cancer, according to research Is published in the Friday edition of Applied and Environmental Microbiology, a journal of the American Society of Microbiology. More information.
5 / 4 / 2017
ONCOLOGISTS ADVERSE FROM THE DANGER OF CANCER MIRACLE PRODUCTS
The Spanish Society of Medical Oncology (SEOM) today warned of the danger that "pseudociences", substances, therapies and "miracle" products against cancer may have, from which it claims that there is "no" preclinical or clinical evidence effectiveness.
1 / 2 / 2017
7 / 4 / 2017
A SPANISH IMPRESSED HUMAN ORGANS IN 3D TO OPERATE CANCER ORGANS
One of the most effective ways to fight cancer is surgery. Darío García is a surgeon and he knows it well; That is why he has created a company based on 3D printing that creates exact replicas of human organs affected by tumors, so that surgeons can emulate with them the steps of the operation that they will perform. Under the name of Cella Medica Solutions, its CEO defines it as a medical solutions company based on 3D technology.
10 / 4 / 2017
26 / 4 / 2017
EXCESSIVE EXPOSURE TO THE SUN INCREASES SKIN CANCER DIAGNOSTICS: HEALTH OR FASHION?
The diagnoses of skin cancer in Spain have increased in recent years. One of the main causes of its occurrence is excessive exposure to the sun and rising temperatures, good weather and closeness to summer make this time the most appropriate to boost its prevention and this Monday is celebrated the European Day of Prevention Of Skin Cancer.
15 / 5 / 2017
THE UNIVERSAL VACCINE AGAINST CANCER, EVERYBODY CLOSER
The journal Nature published this week a study showing a nanoparticle RNA anti-cancer vaccine that leverages the immune system's response to viral infection. The results have shown that the vaccine induces immune responses in mouse tumor models and in three patients with advanced melanoma.
26 / 5 / 2017
HOPE AGAINST LIVER CANCER: HALF PATIENTS SURVIVE WITH IMMUNOTHERAPY
More than half of the patients with advanced liver cancer evaluated have survived more than a year after treatment with an immunotherapeutic drug (nivolumab), supplied in a research developed by the Clinical University of Navarre (CUN) and the CIMA. The trial Has been led by Dr. Bruno Sangro, director of Hepatology at the University of Navarra Clinic, and Ignacio Melero, co-director of the Immunology and Immunotherapy Service of the Clinic and researcher at the Center for Applied Medical Research (CIMA) at the University of Navarra.
30 / 5 / 2017
MORE STEP TOWARDS A UNIVERSAL VACCINE AGAINST CANCER
Cancer is not an invasion of foreign bodies like bacteria or viruses. This disease is a kind of dark back of ourselves, our own crazed cells, which makes it a very difficult enemy to combat. For decades, the most common pharmacological option against the disease has been to poison all cells in the body in the hope that the cancerous ones will suffer more than the healthy ones (chemotherapy). In recent years, however, new, more effective and less toxic options have emerged. More information
31 / 5 / 2017
WHAT ARE FIVE TYPES OF CANCER MORE EASY TO AVOID?
Las células del cuerpo humano se reproducen constantemente, es por eso que en un determinado tiempo acaban por desaparecer. Sin embargo, en algunas ocasiones, en lugar de desaparecer las células se convierten en tejido tumoral. El peligro de esta enfermedad radica en que es muy silenciosa, pero además, el peligro puede resultar mayor, dependiendo del tipo y del lugar del cuerpo en el que se ubique.
1 / 6 / 2017
THE FORMULA TO AVOID THE HALF OF THE DEATHS BY CANCER AND IT ONLY HAS 4 RULES
As much as cancer research has progressed, the disease continues to give us a lot of respect. And is not for less. According to the Spanish Society of Medical Oncology, the risk of presenting cancer before age 75 in Spain is 25.1% and that of dying due to one, 10.2%. Lung cancer is the second leading cause of premature death among Spanish (only behind ischemic heart disease) and colorectal, breast and stomach cancers are in fifth, eighth, and nineteenth position, respectively. More information.
5 / 6 / 2017
GOOD CELLS TO COMBAT CANCER
The human body is constantly fighting the development of cells that give rise to tumors, but when there is an alteration in this process the cancer is free to develop. Researchers at the Walter and Eliza Hall Institute, led by Drs. Sandra Nicholson and Nicholas Huntington, along with colleagues at the Queensland Institute of Medical Research (QIMR), both entities in Australia, are investigating ways to 'turn on' our natural killer cells For its acronym in English, reports Europa Press.
7 / 6 / 2017
I HAVE CANCER. DO YOU HELP ME YOUR IMMUNE SYSTEM?
Oncological diseases were responsible in 2012 for the death of 102,762 people in our country. A figure only surpassed by that associated with cardiovascular diseases and which is mainly explained by the inability of the human immune system to eradicate tumors. In fact, the immune system is in many situations unable not only to fight against tumor cells, but even to recognize them. However, as a new study led by researchers at the Dutch Cancer Institute (NKI) in Amsterdam shows, there is a possible solution for our immune cells to identify tumors as they are: using a 'borrowed' immune system.
9 / 6 / 2017
PHYSICAL EXERCISE REDUCES THE RISK OF DEVELOPMENT OF UP TO 13 TYPES OF CANCER
The practice of physical exercise, as many studies have found, is beneficial to health. And not only because physical activity helps fight obesity and its related diseases - among others, type 2 diabetes, but also because it also reduces the risk of many other pathologies associated with great morbidity and mortality. This is the case, among others and mainly, of cardiovascular diseases, the leading cause of death worldwide with about 17.5 million deaths only in 2012. And, also, many types of cancer.
12 / 6 / 2017
IS THERE TO BE FEAR OF CANCER?
To be born is to begin to die: this is a phrase of affected poet, but also an irrefutable biological fact. In spite of the tragedy of the expression, between one verb and another there is life, much life, which must be satisfied with fullness. About living and about dying and about the disease speaks Manel Esteller Badosa (Sant Boi de Llobregat, 1968), one of the men who know the most about cancer and its mechanisms.
14 / 6 / 2017
INTERNATIONAL CENTER OF CRYOSURGERY REALIZES IN SOME 98% OF THE CASES THE INTERVENTIONS OF BENIGN PROSTHETH HYPERPLASIA
The International Center for Cryosurgery and Criomedicine, based in Malaga, carried out a balance of the first year applying a new technique to treat Benign Prostatic Hyperplasia (Inflammation or Increased Prostate Size) achieving success in 98% of interventions . Patients in addition to not needing surgery maintain intact their sexual functions.
16 / 6 / 2017
NEW EUROPEAN CODE OF MEASURES AGAINST CANCER
The International Agency for Research on Cancer (IARC) today presents the fourth edition of the European Code against Cancer in Spain with the participation of the Spanish Society of Epidemiology.
19 / 6 / 2017
CONTAMINATION INCREASES THE MORTALITY OF ALL TYPES OF CANCER, NOT ONLY LUNG CANCER
Pollution is, rather than harmful to health, directly fatal. Not in vain, this air pollution is responsible every year for the death of more than 25,000 people in our country alone. In fact, the inhalation of particles in suspension with a diameter not exceeding 2.5 microns - PM2,5, which are considered the best indicator of urban pollution and whose small size poses a greater risk to the health of humans - causes diseases such as, among others, cardiovascular, respiratory and cancer. In fact, a new study led by researchers at the University of Birmingham (UK) warns that each increase of 10 micrograms per cubic meter of air at PM2.5 levels leads to a 22% increase in the risk of mortality by any Type cancer in the population over 65 years. A very important aspect to keep in mind given that, to date, 1 in 3 Spaniards are forced to breathe contaminated air.
21 / 6 / 2017
GENETIC COPY AND PASTE ALSO IN THE SERVICE OF CANCER
In an old candy factory, not far from the Massachusetts Institute of Technology (Cambridge, USA), Yi Yang sits in front of a laminar flow hood to manipulate a transparent tray. Submerged in a fuchsia fluid, millions of tumor cells are expected to be manipulated with fashion technology in laboratories around the world, CRISPR, a kind of genetic editing that has also been put to the service of Oncology.
23 / 6 / 2017
26 / 6 / 2017
INTESTINAL BACTERIA COULD HELP PREVENT CANCER, ACCORDING TO A STUDY
Researchers have shown that various types of intestinal bacteria could be factors that cause and prevent obesity and other disorders and diseases. Now, a study by the University of California-Los Angeles (UCLA) in the United States suggests that they could also potentially be used to reduce the risk of some types of cancer.
28 / 6 / 2017
MARRIAGE PROLONGES THE SURVIVAL OF PATIENTS WITH CANCER
The survival of patients with cancer is conditioned by a multitude of factors. This is, of course, the case for the effectiveness of treatments, which play a crucial role in preventing or delaying mortality from the disease. However, there are other factors that also drastically influence this survival. This is the case, among others, of the support, both physical and emotional, that patients receive. In fact, a new study led by researchers at the California Cancer Institute in Fremont (USA) and published in the journal Cancer shows that, given a cancer diagnosis, married patients have a much higher probability To live longer than those who have remained single.
30 / 6 / 2017
NEURODEGENERATIVE DISEASES WILL CAUSE MORE DEATHS THAN CANCER
The scientist Javier Herrero, a member of the Institute of Neurosciences of Castilla y León (Incyl), today highlighted the importance of donating the brain to be able to move forward against neurodegenerative diseases, which by the middle of this century will cause more deaths than cancer.
18 / 9 / 2017
SATELLITES SPY OF CANCER
Cancer is a disease of the genome. Today scientists know the enemy much better than before and know that behind a seemingly identical tumor in the lung - colon, pancreas, brain - two patients hide two potentially very different problems. The many genetic pathways that lead to a cell escaping from the iron biological program that controls its growth and division to become cancerous, though not infinite, are enormous.
20 / 9 / 2017
STUDY THE RELATIONSHIP OF ANISAKIS WITH GASTROINTESTINAL CANCER
A group of Spanish researchers have detected antibodies against anisakis in patients with gastrointestinal cancer, which has led them to investigate to what extent anisakis should be considered as a possible risk factor in the development of this type of cancer.
22 / 9 / 2017
TAKING COFFEE DAILY REDUCES THE RISK OF COLORCECTAL CANCER
Each year around 33,000 new cases of colorectal cancer are diagnosed in our country, accounting for around 15% of all new oncological diagnoses. In fact, colorectal cancer is the most common tumor in Spain combining both sexes, as well as the second in mortality after lung cancer, causing each year about 15,000 deaths.
25 / 9 / 2017
DISCOVERED A NEW DRUG AGAINST A TYPE OF METASTATIC COLON CANCER
Scientific research has again shed some light on the fight against colon cancer, one of the most common tumors in Spain and the leading cause of cancer death when men and women are added. Researchers at the Hospital del Mar in Barcelona have identified a new drug (the Sym004) against a type of metastatic cancer that had no further therapeutic course when conventional drugs failed.
27 / 9 / 2017
COLON CANCER, PREVENTION BEGINS ON DIET
In Spain is the second most diagnosed cancer in women after the breast and the third in men after the prostate and lung. It is also the tumor that causes more deaths, only behind the lung. It's colon cancer. Today is the World Day of this disease. Its high lethality has to do with that for a long time can go unnoticed.
29 / 9 / 2017
4 / 10 / 2017
NEW TREATMENT REDUCES POLYMERS IN HEREDITARY COLORCARDAL CANCER PATIENTS
Inheriting a mutation in the APC gene leads to a lifetime risk of nearly 100% colorectal cancer. While colon cancer can be kept at bay by elimination of the large intestine, these patients also have a risk of up to 15% developing cancer in the small intestine, which is the leading cause of cancer death in this group of patients.
6 / 10 / 2017
CEREBRAL METASTASIS IN LUNG CANCER WITH SILIBININE REDUCES 70%
Researchers at the Catalan Institute of Oncology (ICO) in Girona have been able to reduce brain metastasis in patients with lung cancer by more than 70% thanks to silibinin, a natural substance extracted from the borriquero thistle, sources at the Institute have reported.
11 / 10 / 2017
DISCOVER THAT THE BORRIQUERO CARDO BRAKES THE CEREBRAL METASISIS OF LUNG CANCER
The benefits of the antioxidant properties found in thistle (silybum marianum) are well known. This plant up to three meters high and Mediterranean climate - which is also called borriquero thistle or burrero - can be used as a laxative, antihemorrhagic, reduces excess iron, reduces cholesterol, is beneficial against diabetes, is used for vipers and insect bites and also helps with menstrual problems.
16 / 10 / 2017
TREATMENT ELIMINATES POLLOPS IN PATIENTS AT HIGH RISK OF COLORCECTAL CANCER
Familial adenomatous polyposis (FAP) is an uncommon hereditary disease characterized by the appearance of more than one hundred benign polyps in the colon and rectum after the second decade of life. The problem is that, once over thirty, the risk that any of these polyps will become malignant is very high, to the point that those affected by PAF have a risk close to 100% of developing colorectal cancer at some point of his life unless he undergoes colectomy - removal of the colon.
18 / 10 / 2017
DISCOVER THE GENE THAT WOULD CAUSE BREAST CANCER
The gene called GT198 is usually a good gene, which repairs chromosomal damage and prevents disease. But when it mutates, that is to say it changes its conformation due to genetic or environmental factors, it has an enormous harmful potential: it could cause that begins to develop a breast cancer of precocious form.
20 / 10 / 2017
A BRA WHICH DETECTS BREAST CANCER? SCIENTISTS ARE ALREADY WORKING ON IT
According to the Spanish Cancer Association (AECC), 26,000 cases of breast cancer are detected every year in our country, almost 30% of all female tumors. But the AECC is also positive, as the latest data indicate that survival for this tumor increases by 1.4% annually, partly because each year multiplies information on the importance of early diagnosis.
23 / 10 / 2017
ANNUAL BUCODENTAL REVIEWS IMPROVE EARLY CANCER DIAGNOSIS
Oral cancer, which originates in the mouth or the lips, affects 3 percent of the population in Spain but with an oral revision each year could be diagnosed early and prevent it from being more aggressive, according to Néstor Montesdeoca, head of the Oral and Maxillofacial Surgery Service at the MD Anderson Cancer Center in Madrid.
25 / 10 / 2017
DEVELOP A DRUG THAT GENERATES NANOPARTICLES TO CURE CANCER
Scientists have created an injectable drug that generates nanoparticles capable of facilitating the cure of tumor metastasis in the lungs and liver of mice, according to a study published today by the journal Nature. The research, developed by experts at the Houston Methodist Institute (HMRI), could radically transform the treatment of triple negative breast cancer that has spread to the lungs and liver, officials said.
30 / 10 / 2017
THE PROTECTIVE EFFECT OF PHYSICAL ACTIVITY AGAINST BREAST CANCER IS NOT LINKED TO THE DENSITY OF THE BREAST
A detailed large-scale study of a group of Danish researchers has found that there is no relationship between physical activity and breast density. Their authors point out that their findings imply that the protective effect of physical activity on breast cancer could be through other mechanisms other than breast density.
3 / 11 / 2017
THE MARKER THAT OPTIMIZES THE EFFICACY OF IMMUNOTHERAPY FOR CANCER
The results of a new study published in the journal "Science" underscore the importance of the role of tumor neoantigens in the response of cancer patients to immunotherapy, the most promising treatment for cancer. The neoantigens, called 'seeds' are biological markers that are only found in cancer cells, and according to the authors of this work there are some types of cancer that contain in themselves this seeds for their own destruction, something that would allow specific treatments according to the immune systems of patients.
6 / 11 / 2017
SPANISH RESEARCHERS FIND WHY APNEA ASSOCIATES TO A WORST EVOLUTION OF CANCER
Obstructive sleep apnea is a disorder characterized by continuous interruptions of breathing during sleep. A disorder that suffers about 6% of the world population and that, far from being limited to a worsening of the quality of rest of those affected, is associated with an increased risk of diseases, in the case of cardiovascular diseases -among others, hypertension arterial pressure, myocardial infarction and stroke.
8 / 11 / 2017
MYC, THE GENE THAT HELPS CELLS OF CANCER TO EVADATE FROM THE IMMUNE SYSTEM
An old acquaintance, the MYC oncogene, seems to be the most responsible for cancer cells hiding from the immune system and can continue to develop. This ally of cancer, according to a study published in "Science", helps tumor cells survive in hostile environments by increasing the expression of two proteins that hinder the ability of the immune system to destroy tumors.
10 / 11 / 2017
NEW WAYS TO OVERCOME CANCER
Nobody doubts that one of the most dramatic aspects of cancer are the effects of some treatments to fight it. In fact, conventional radiotherapy and chemotherapy are usually administered systemically, altering the entire organism and not just the areas affected by malignant tumors. And while the results can be, in many cases, good against the disease, it also occurs that healthy organs and structures are affected.
13 / 11 / 2017
COLOMBIAN INVESTIGATORS DESIGN A BRAKE THAT DETECTS BREAST CANCER
A group of researchers from the National University of Colombia (UN) has designed a bra that helps detect breast cancer to determine the difference in temperature in both breasts, caused mainly by the presence of abnormal cells. The system, which is currently a prototype, aims to innovate in the prevention of the disease, whose late diagnosis can complicate the treatment and reduce the chances of success, explained the UN in a statement.
15 / 11 / 2017
DETERMINE THE GENES RESPONSIBLE FOR A VERY COMMON LEATHER CANCER
Basal cell carcinoma is one of the most common types of skin cancer. S estimates that 90% of the population is at risk of developing it sometime during their life, especially due to age and exposure to UV rays from the sun. Although common, this type of cancer is rarely fatal, and so far has been little studied.
17 / 11 / 2017
RADIOTHERAPY FOR PROSTATE CANCER COULD CAUSE OTHER TUMORS
In our country, more than 25,000 new cases of prostate cancer are diagnosed every year, the most prevalent type of tumor in the male population. A tumor whose treatment requires surgery or the administration of radiotherapy, very aggressive interventions associated with numerous side effects, case of urinary incontinence and erectile dysfunction.
20 / 11 / 2017
GREASE FAVORS COLON CANCER AND NOW WE KNOW WHY IT OCCURS
Eating little, without falling into malnutrition, seems to date the best recipe to live longer and keep the disease away. And if in addition to reducing the amount of calories, we avoid fats, the chances of a tumor appearing are reduced even more. For years scientists who try to solve the puzzle of cancer know that obesity and high-fat diets are not limited to clog arteries, also raise the chances of suffering from certain tumors such as digestive. But to date, it was not known why. The molecular and cellular explanation is revealed in a study published by the journal «Nature».
22 / 11 / 2017
SCIENTISTS DISCOVER HOW PHYSICAL ACTIVITY PROTECTS AGAINST CANCER
Practicing physical activity has an immunotherapy effect that prevents the appearance of cancers and, in the case that they have already appeared, helps to slow down their progression. It is the conclusion reached by researchers from the University of Copenhagen (Denmark) who have studied the effects of physical activity in mice bred to develop melanomas, lung cancers and liver cancers.
27 / 11 / 2017
DOGS DETECT CANCER
Dr. Claire Guest reviews the photos stored on her mobile. Suddenly he finds the one of a tanned labrador and stops. "This is my dog Daisy," she shows proudly during one of the breaks of the Better with Pets conference, organized this week in Brussels.
29 / 11 / 2017
NOW WE CAN CHOOSE CUSTOMIZED THERAPIES FOR EACH TYPE OF CANCER AND PATIENT
The Medical Oncology service of the Hospital Miguel Servet of Zaragoza turns 25, a time in which this department has expanded to deal with a pathology that continues to increase but before which specialists have more and more tools in the therapeutic offer. "This is thanks to the growing knowledge of the tumor", says Dr. Antonio Antón, head of this service. The key to this specialist is in improving knowledge of the molecular biology of cancer that has allowed specialists to have therapeutic alternatives that they did not have before. "In the end, we are personalizing the treatment to give the best we have to those patients who need it" he concludes.
30 / 11 / 2017
A LASER SYSTEM CAN IMPROVE THE EFFICACY OF TREATMENTS FOR CEREBRAL CANCER
A laser system used to treat tumors in the brain can "open a temporary window" in the protective barrier of this organ and allow it to reach chemotherapy drugs against a type of cancer, according to a study published by Plos One.
4 / 12 / 2017
INTERNATIONAL CENTER FOR CRYOSURGERY AND CRYOMEDICINE, PIONEER IN TREATING PROSTATE PROBLEMS BY MAINTAINING SEXUAL FUNCTION
The International Center for Cryosurgery and Criomedicine (ICCC) is a pioneer in applying a new treatment with gases at low temperature to treat benign prostatic hyperplasia with good results and encouraging the patient to maintain all their sexual functions, as this does not lose erection or ejaculation.
11 / 12 / 2017
CRYOSURGERY, AN ADVANCED METHOD AGAINST CANCER
According to experts, at some point in their lives, almost 40 percent of the population develops some type of cancer, and in more than half of the cases this disease is curable if it is diagnosed in time.
29 / 12 / 2017
FULL EFFECTIVENESS IN LASER TREATMENT FOR WOMEN WITH BREAST CANCER
Members of the International Center Cryosurgery, with Dr. Pedro Torrecillas Malaga, urologist and member of the European Academy of Sciences, Arts and Letters; took part
in a prestigious international event.
21 / 1 / 2016
GALICIAN SCIENTISTS, IN THE EPICENTER OF CANCER RESEARCH
According to El Faro de Vigo, the research group of the University of Santiago de Compostela (USC), BioFarma, has just joined a project that explores the role of new inhibitors aimed at epigenetic targets against cancer, led by the company Oryzon Genomics, with which he has already collaborated since 2008 in other projects. "We intend to act on certain proteins that modulate the expression of certain genes related to cancer without modifying the information contained in the DNA", explains Mabel Loza, coordinator of the BioFarma group, applied to the discovery of drugs, regarding this study.
15 / 12 / 2017
A TEST WHEN DIAGNOSING BREAST CANCER PREDICTS HOW THE TREATMENT WILL GO
According to El Periódico de Catalunya, a genomic test performed at the time of the diagnosis of a breast cancer predicts the prognosis and the response to treatment with chemotherapy, according to a study conducted by doctors and researchers from the Hospital Clínic and the Idibaps (Instituto de Agustí Pi i Sunyer Biomedicine Research) of Barcelona.
18 / 12 / 2017
12 / 1 / 2016
THE DOCTOR PEDRO TORRECILLAS IN THE PROGRAM 'LA SALUD A TODA COSTA'
Dr. Pedro Torrecillas, as medical coordinator of the International Center for Cryosurgery, and the Urology Center of Malaga, presented in the program 'La Salud a Toda Costa' of 101 TV all the advances that cryosurgery has shown in recent years; especially in prostate cancer.
20 / 12 / 2017
UROLOGIST PEDRO TORRECILLAS PARTICIPATED IN TWO KEY INTERNATIONAL QUOTATIONS FOR THE FUTURE OF CRYOSURGERY IN TUMOR TREATMENT
Dr. Pedro Torrecillas, urologist member of the European Academy of Sciences, Arts and Letters, will participate in this month of October in two prestigious international meetings; but also of great importance for the future of cryosurgery and cryomedicine in the treatment of tumor diseases
22 / 12 / 2017
INTERNATIONAL CENTER FOR CRYOSURGERY IMPLEMENTS A METHOD THAT ALLOWS PATIENTS OF BENIGN PROSTATE HYPERPLASIA TO PRESERVE ALL THEIR SEXUAL FUNCTIONS
International Center for Cryosurgery and Criomedicine, based in Malaga, has presented a new technique to treat Benign Prostatic Hyperplasia (Inflammation or Increase in Prostate Size) in a way that increases the patient's quality of life and keeps their functions intact sexual
27 / 12 / 2017
Dr. PEDRO TORRECILLAS, ACADEMIC OF THE EUROPEAN ACADEMY OF SCIENCE, ARTS AND LETTERS
Dr. Pedro Torrecillas has already been named Academician of the European Academy of Sciences, Arts and Letters. The official appointment and the first working session took place in the French Senate, in Paris, where he shared Assembly and seating with personalities from the most diverse scientific fields and with more than 30 Nobel prizes.
29 / 12 / 2017
THE CRIOCIRUGIA AND DR. PEDRO TORRECILLAS, PROTAGONIST IN THE DIARY 'EL MUNDO'
The International Center for Cryosurgery and Criomedicine, as well as its medical director, Dr. Pedro Torrecillas were the main protagonists of an extensive interview that has been published this month by the newspaper El Mundo. After a review of his entire career, Torrecillas analyzed the challenges that will be addressed in the coming months, all aimed at reducing risks and increasing treatment options in different types of cancers and tumors.
25 / 11 / 2016
3 / 7 / 2014
23 / 6 / 2014
Doctor Torrecillas, passion for innovation
We do not know if medical journals The Lancet, New England Journal or Medicine Clinic, we have collected. But of coursethe work of Dr. Pedro Torrecillas (and Dr. Lugnani) deserve to be highlighted in them justly. You should not overlook theinnovative technique based on cryosurgery, a procedure that causes selective destruction of diseased tissues usingfreezing temperatures.
23 / 6 / 2014
Malaga opens the door to a new cancer therapy
Haakon Radge The American Foundation, one of the largest centers of study and research of cryosurgery (freezing technique to destroy cancer cells), has chosen the medical team Cryosurgery Malaga Clinic based in Santa Elena de Torremolinos, as partner Referring to implant in Europe a technique using dendritic cells (charge of defense) to increase the responsiveness of patients.
23 / 6 / 2014